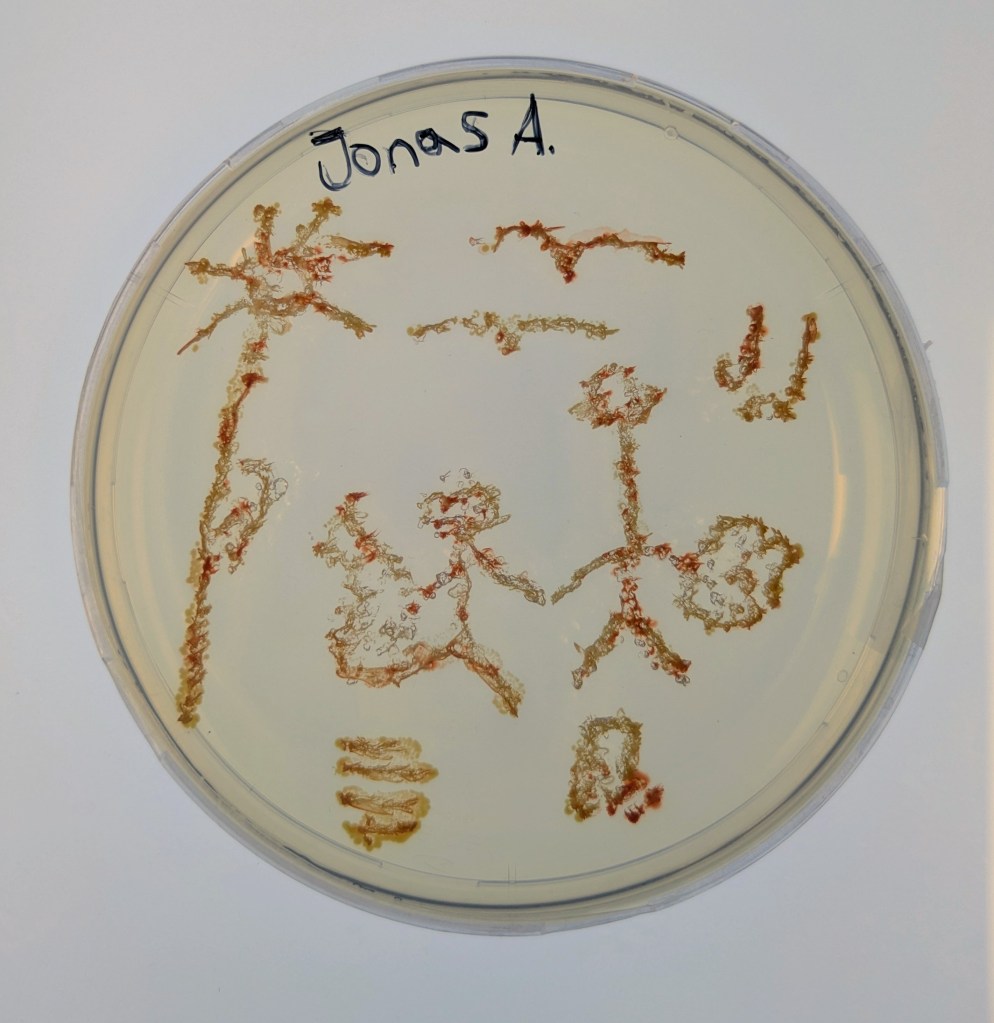
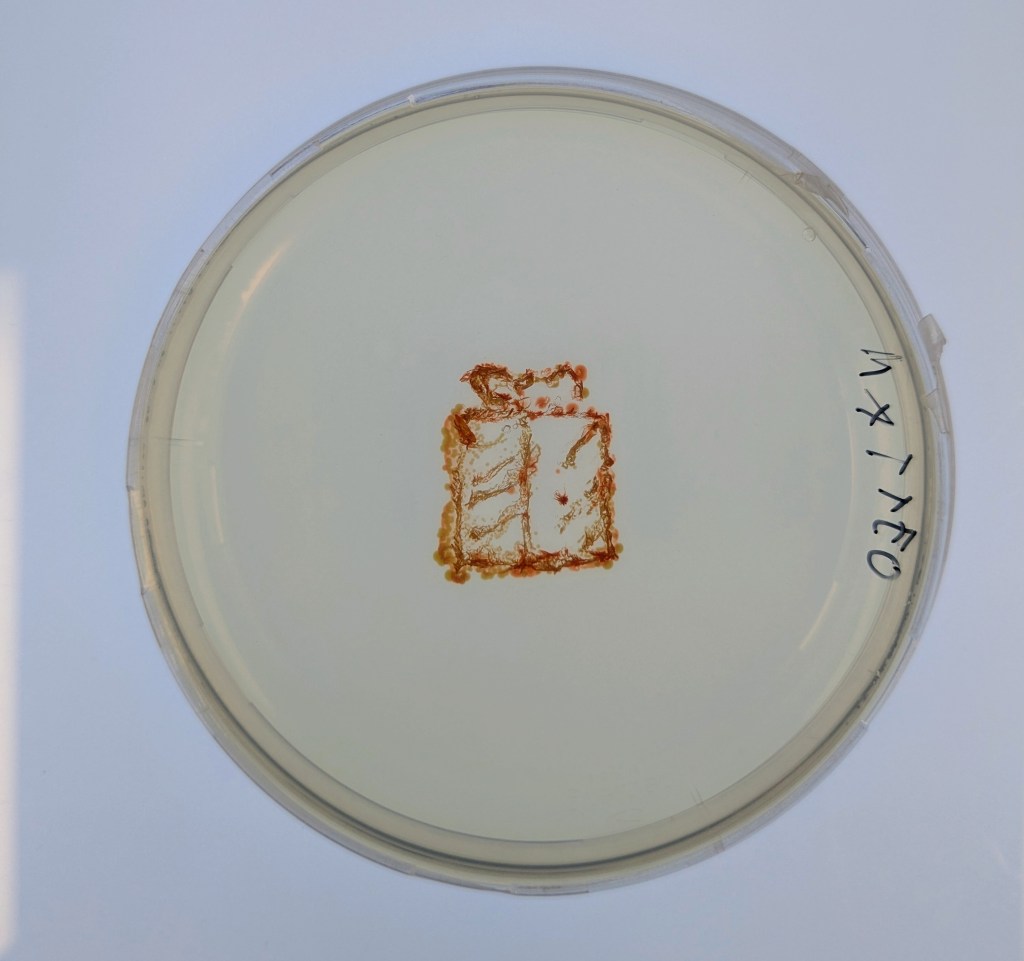
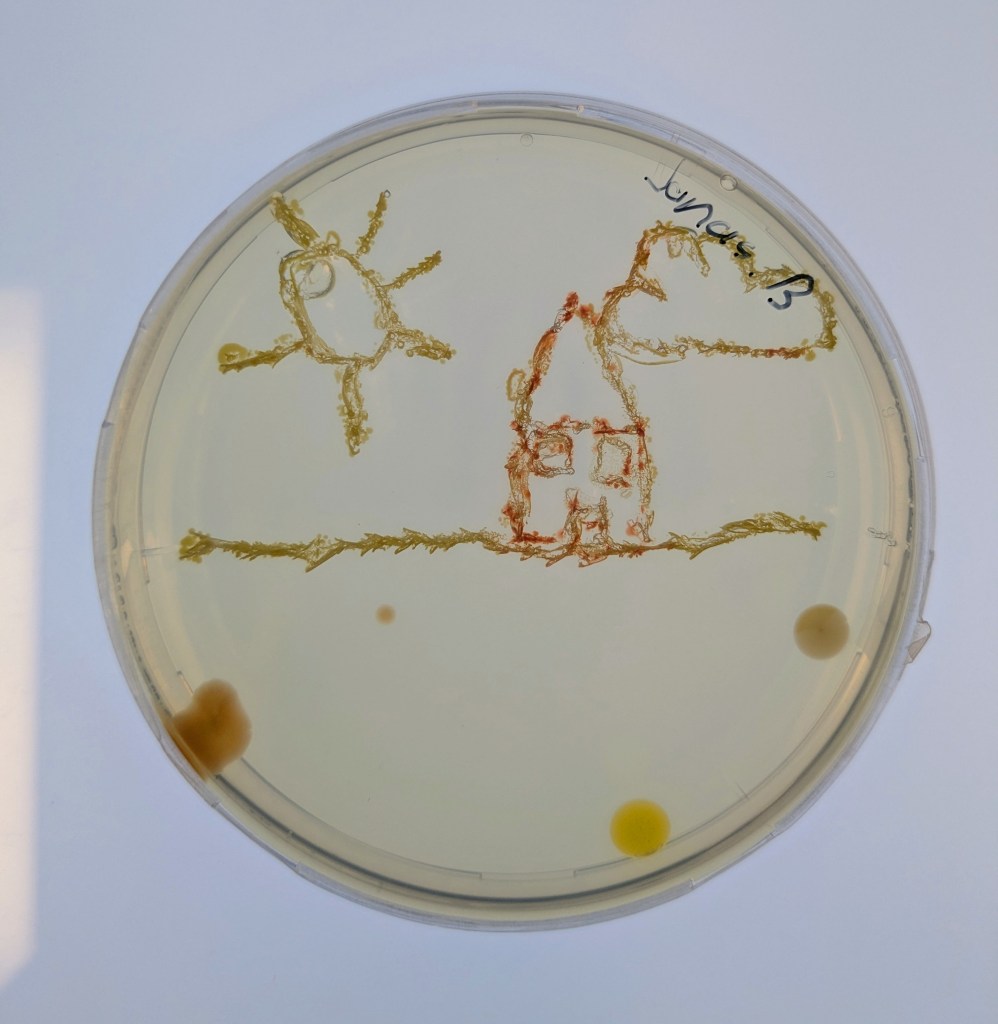
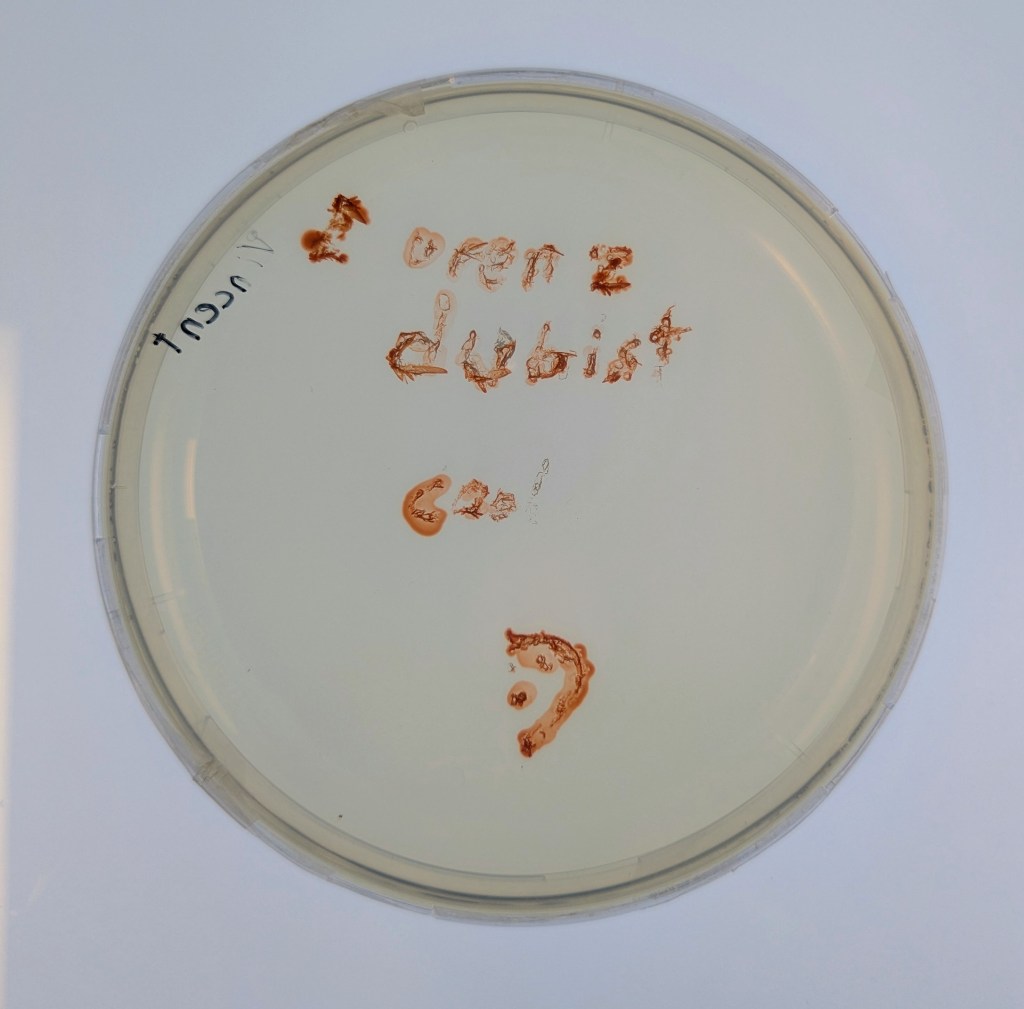

Klasse 3c (2024/2025) mit Matthias Hötzinger

1. Workshop mit Probenahme
Im April 2025 waren wir zu Besuch im BRG Schloss Wagrain. Unser Projekt läuft nun schon zweieinhalb Jahre und die Klasse 3c ist neu im Projekt dazugekommen. Die Klasse will uns bei der Suche nach Artnamen für unsere restlichen noch zu beschreibenden neuen Bakterienarten unterstützen. Darüber freuen wir uns sehr 🙂 .
Zuerst gab es einen kleinen Vortrag von uns und wir waren sehr erstaunt, was die Schüler/innen schon alles wussten. Sogar den sogenannten Tree of Life, der alle auf der Erde lebenden Organismen darstellt, kannten die Schüler/innen. An ihm kann man die ungeheure Vielfalt der Bakterien sehr schön sehen. Er zeigt auch, dass die Lebewesen, die wir mit blosem Auge sehen können und zu denen auch der Mensch gehört, nur einen kleinen Teil der Biodiversität darstellen. Dafür war neu, dass von den vermutlich Milliarden existierenden Bakterienarten nur ca. 20.000 der Wissenschaft namentlich bekannt sind. 13 neue Arten sind bis jetzt durch unser Projekt und die Mithilfe unserer Citizen Scientists bereits dazugekommen. Nach ein paar Experimenten zu Leitfähigjkeit und pH-Wert im Klassenzimmer ging es an Ager und Vöckla um Wasserproben zu holen und Messungen vor Ort durchzuführen. Die Wasserproben haben wir später im Labor aufbereitet. Wir wollen eine Methode entwickeln, um unsere Aquirufa Bakterien und ihre verschiedenen Arten direkt aus der Erbsubstanz in der Wasserprobe nachzuweisen. Da wartet allerdings noch sehr viel Arbeit auf uns. Der absolute Höhepunkt war aber die Messung der Fließgeschwindigkeit mit Hilfe eines fluoreszierenden Farbstoffes in der Ager (mit Ton anschauen 😉 ):
Wir sind sehr gespannt auf die Artnamen und freuen uns auf den Besuch der Klasse bei uns in Mondsee im Herbst. Ein paar Eindrücke von der Exkursion:
2. Besuch in Mondsee
Im November 2025 war die Klasse bei uns in Mondsee im Forschungsinstitut für Limnologie zu Besuch. Mit dabei war auch ihr Klassenvorstand Brigitte Lumpi. Die Klasse hatte uns im Frühjahr bei der Probenahme an Ager und Vöckla geholfen und für unsere neuen Arten vier Namen kreiert. An vier Stationen wurde das Institut erkundet. Frisch gefangenes Mondsee Plankton wurde unter der Stereolupe bewundert. Besonders beeindruckend waren räuberische Wasserflöhe der Gattung Polyphemus. Sie besitzen ein großes, schwarzes Auge, womit sie ihre Beute gut sehen können. Ein Schüler entdeckte sogar einen Süßwasserpolypen. Im Bootshaus wurde die Probenahmegeräte ausprobiert. Bei einer Führung durch das Institut wurden Kulturräume und Labore besichtigt. Aber das Highlight war unser Labor, wo die Schüler:innen mit unseren roten Aquirufa-Kulturen malen durften. Anschließend gab es noch Partybrezeln (für manche das persönliche Highlight;-)), bevor es wieder mit dem Bus nach Vöcklabruck zurück ging.
Wir sagen fürs erste Danke fürs Mitmachen und melden uns sobald die Ergebnisse durch die Mitarbeit der Klasse in einer wissenschaftlichen Fachzeitschrift veröffentlicht werden.